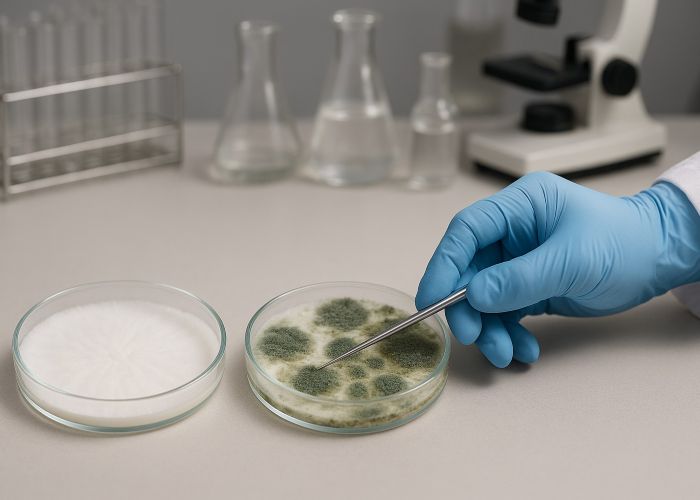

Грибоводи можуть пробачити багато — легку бактеріальну пляму, невеликий застій, пересушений кейк, дивний, «замислений» міцелій, який просто потрібно почекати. Навіть перші ознаки дріжджового зараження іноді сприймаються без паніки — є шанс локалізувати, стримати, обійтися малими втратами. Але є контамінант, після появи якого в гровера вже немає простору для маневру. Пухнастий наліт білого кольору з ледве помітною зеленню — сигнал, який завжди означає одне: все закінчено. Це триходерма.
І якщо для садівників та агрономів вона може бути корисною — адже з патогенами рослин триходерма бореться блискуче — то для міколога вона не просто ворог, а абсолютна загроза.
Знайомтесь: триходерма
Триходерма — це не просто пліснява, а цілий рід грибів (Trichoderma), представники якого поширені повсюдно: у ґрунті, на гниючій деревині, у компості, в гної та, на жаль, — на ваших субстратах, якщо стерильність була порушена хоча б один раз. У контексті грибівництва найчастіше фігурують T. harzianum, T. viride і T. aggressivum — види, які стали сумно відомими тим, як швидко та ефективно знищують міцелій псилоцибінових грибів.
Особливу небезпеку триходерма становить для культур Psilocybe cubensis, P. cyanescens і P. azurescens. Ці гриби чутливі до конкуренції й не мають захисних механізмів проти ферментної агресії. А саме цим і відрізняється триходерма: вона не просто витісняє міцелій, вона його розчиняє. Секреція хітиназ, глюканаз, целюлаз та інших літичних ферментів дає їй змогу руйнувати клітинні стінки чужих гіф, проникати всередину й буквально живитися міцелієм конкурента.
З наукового погляду цей механізм називається мікопаразитизмом — коли один гриб паразитує на іншому. Але в умовах домашнього гроубоксу це означає катастрофу. Триходерма не просто з’являється — вона атакує, захоплює, спорулює та перетворює інкубаційне приміщення на мінне поле.
Чому вона небезпечніша за всі інші забруднювачі
Серед багатьох контамінантів, із якими може зіткнутися грибовод, триходерма — по праву найпідступніша й найруйнівніша. Причина не в якомусь одному її властивості, а в поєднанні факторів, що роблять її практично ідеальним біологічним загарбником. Ось що робить її особливо небезпечною:
Феноменальна швидкість росту.
На живильному середовищі триходерма розвивається у кілька разів швидше, ніж міцелій Psilocybe cubensis. За добу вона може покрити значну частину субстрату, а через дві — повністю його захопити. Жоден вид псилоцибінових грибів не здатен рости з такою швидкістю, особливо на початкових стадіях.
Складність діагностики на ранній стадії.
Візуально молодий міцелій триходерми схожий на здоровий грибний міцелій. Такий самий білий, пухнастий, «перспективний». І тільки уважне око помітить відмінності: пухкість, відсутність блиску, відсутність ризоморфних ниток. Поки ви сумніваєтесь — вона вже діє.
Стійкість до термообробки.
Спори триходерми легко переживають пастеризацію, а в деяких випадках — і неповну стерилізацію. Особливо це стосується субстратів із щільною структурою або високою вологістю. Звичайної термічної обробки часто виявляється недостатньо.
Біохімічна агресія.
Навіть без прямого контакту триходерма здатна пригнічувати ріст Psilocybe. Вона виділяє токсини та органічні кислоти, які гальмують міцелій, змінюють pH середовища, порушують ферментативну активність. Це робить її особливо небезпечною на стадії інкубації — міцелій може зупинитися в рості ще до візуального контакту.
Спороношення — найнеприємніший етап.
Як тільки ви бачите зелений порошковий наліт на поверхні — усе, спори вже в повітрі. Вони мікроскопічні, леткі й осідають усюди: на одязі, волоссі, стінках боксу, усередині фільтрів, на інструментах. Після цього все приміщення стає потенційною зоною зараження. Навіть нова, ідеально стерильна партія буде під загрозою, якщо не провести глибоку санацію.
Як вона проявляється: від невинної плями до колоніального захоплення
Перші ознаки зараження — невеликий білуватий наліт. Він може бути настільки схожим на звичайний міцелій, що навіть досвідчені грибоводи не завжди одразу реагують. Але минає день-два, і структура стає пухкою, а потім набуває типового зеленого відтінку.
Якщо до цього моменту триходерма вже проросла всередину субстрату — гру закінчено. Навіть видалення ураженої частини та дезінфекція поверхні не врятують, тому що грибниця вже захопила кейк ізсередини. А спори, швидше за все, уже в повітрі.
Типові помилки, що сприяють зараженню
Навіть досвідчені грибоводи можуть допустити промахи, які створюють ідеальні умови для триходерми. Вона не вимагає багато: достатньо одного слабкого ланцюга — і зараження стає лише питанням часу. Ось найпоширеніші помилки, що відкривають їй шлях:
Недостатня термообробка субстрату.
Багато хто вважає, що 60 хвилин на парі — досить. На жаль, це міф. Спори триходерми часто переживають пастеризацію при 65–70 °C. Щоб справді їх знешкодити, потрібна стерилізація в автоклаві або скороварці при температурі 121 °C не менше 90 хвилин. Особливо це критично під час роботи з щільними субстратами, де внутрішні шари прогріваються повільно.

Порушення асептики під час інокуляції.
Відкривання банок у «чистому» приміщенні, але без ламінарного потоку або хоча б полум’я пальника — пряма загроза. Робота голими руками, без маски, з неперевіреними інструментами — також. Спора триходерми може потрапити всередину за частку секунди, і ви дізнаєтесь про це вже після інкубації.
Повторне використання субстрату.
Навіть якщо він виглядає чистим і «не пахне» — спори можуть ховатися в мікропорах і капілярах. Без повноцінної стерилізації повторно використаний субстрат — чудове середовище для спалаху триходерми, особливо якщо раніше в партії вже були ознаки зараження.
Надмірне зволоження субстрату.
Вологість вище 70–75% без належної вентиляції перетворює субстрат на розсадник плісняви. Триходерма обожнює такі умови: насичене вологою середовище без кисню в нижніх шарах — ідеальний старт для її гіф.
Чи можна боротися з триходермою?
Коротка відповідь — ні, якщо йдеться про заражений субстрат. З триходермою не борються, її попереджають. Усі спроби «вилікувати» кейк із ознаками зараження — це самообман і відвертий ризик для всієї інкубаційної зони.
Навіть якщо ви зрізали зелену ділянку, обробили її сіллю, гіпсом, оцтом, фунгіцидом або перекисом — спори вже могли проникнути вглиб. Гіфи триходерми часто поширюються на мікроскопічному рівні ще до появи видимого нальоту. Помітна колонія — це лише вершина айсберга. Основна маса гіф уже всередині й продовжує рости.
Особливо небезпечно сподіватися на «точкове порятунок», якщо вже почалася споруляція. Зелений наліт — це не просто візуальний дефект, а величезна кількість летких спор, які миттєво поширюються повітрям, осідають на фільтрах, стінках, інструментах, одязі та можуть «перескочити» на нові кейки або банки ще до того, як ви помітите їхню появу.
Єдина правильна тактика у випадку зараження — повна утилізація. Герметично закрити кейк або банку, не відкриваючи в приміщенні, винести з зони культивації та утилізувати. Після цього — провести тотальну санацію інкубаційного простору: обробити всі поверхні спиртом, перекисом, засобами з хлором або озонатором, замінити фільтри та мембрани, продезінфікувати повітря, змінити робочий одяг.
Що допомагає уникнути зараження
Запобігти зараженню триходермою — завдання цілком реальне, якщо вибудувати системну профілактику. На відміну від боротьби з уже проявленим осередком, профілактика ефективна та надійна. Її основа — три ключові принципи: чистота, термічна обробка та грамотна організація простору.
-
Чистота
Це перший і головний рубіж оборони.
Усе, що контактує з культурою, має бути або стерильним, або продезінфікованим. Обробка рук і інструментів спиртом або хлоргексидином, обов’язкове використання рукавичок і маски, лише стерильні шприци та голки. Робоча зона — ламінарний бокс або хоча б стерильна камера. Будь-яке відкриття банок, робота з інокулянтами чи пересів — лише в контрольованому середовищі. Пил, одяг, дихання — усе може нести спори. -
Термічна обробка
Ніякого «на око» чи «достатньо гаряче». Тільки повноцінна стерилізація. Особливо це важливо для субстратів на основі зерна, кокосу, паперу, тирси, соломи — саме вони найчастіше стають плацдармом для триходерми. Скороварка або автоклав, температура не нижче 121 °C, не менше 90 хвилин. Краще перестрахуватись, ніж втратити партію через тиждень. -
Зонування
Класична помилка — поєднання інокуляції та плодоношення в одному приміщенні. Здавалось би, зручно. На практиці — прямий шлях до перехресного зараження. Спори, що з’явились у зоні плодоношення, легко потрапляють в інкубаційний бокс, особливо при порушенні повітряного потоку. Будь-яка спора на краю фільтра — і наступна партія вже заражена з моменту засіву.
Додаткові заходи:
- Регулярне провітрювання інкубаційних камер (із фільтрацією повітря).
- Встановлення HEPA-фільтрів на вхідні та вихідні канали.
- Підтримання стабільної вологості (60–65%), без надлишкового конденсату.
- Обережна робота з субстратом: не переущільнювати, не переливати водою. Щільний, вологий, погано дихаючий кейк — ідеальне укриття для спор.
Цікавий парадокс
Триходерма — дивовижний організм: те, що робить її смертельно небезпечною в грибівництві, в агрономії перетворює її на союзника. У біотехнологіях її активно застосовують для створення біофунгіцидів, як компонент компостних прискорювачів і навіть як пробіотик для кореневої зони. У сільському господарстві Trichoderma harzianum та її «сестри» захищають томати, огірки, виноград та інші культури від патогенів на кшталт Fusarium, Pythium і Rhizoctonia. Їхня ферментативна активність використовується на благо — для захисту, стимуляції росту та стабілізації мікробного фону в ґрунті.
Але в мікології все навпаки. Для Psilocybe cubensis та інших псилоцибінових грибів триходерма — не просто конкурент, а кат. Міцелій псилоцибінових грибів не має жодних механізмів захисту від літичної атаки, не виділяє антагоністичних метаболітів і не здатен протистояти зміні pH. Те, що допомагає кореневій системі томата, повністю руйнує міцеліальну структуру Psilocybe.
Тому так важливо не переносити агрономічні практики в мікологічні. Добавки на основі T. harzianum, створені для розсади, теплиць і відкритого ґрунту, можуть стати причиною повного краху грибної інкубації. Це не просто «невдала добавка» — це пряма загроза. Парадокс, у якому одна й та сама пліснява рятує одні культури й знищує інші, — наочний приклад того, наскільки контекст важливий у роботі з мікроорганізмами.
Підсумовуючи
Триходерма — це не просто одна з можливих плісняв. Це повноцінний противник із набором властивостей, які роблять її майже ідеальною формою біологічної загрози для грибоводів. Вона діє швидко, руйнує міцелій не лише фізично, а й біохімічно, стійка до термічної та хімічної обробки, і найголовніше — спорує в повітрі, перетворюючи зараження з локальної проблеми на системну.
Кожен, хто працює з псилоцибіновими грибами, рано чи пізно стикається з цим ворогом. Це майже ритуальне посвячення в мікологію. Але різниця між тими, хто втрачає все, і тими, хто рухається далі, — у готовності. Готовності дотримуватись стерильності, грамотно обробляти субстрати, розділяти зони, працювати в рукавичках, масці та не нехтувати дрібницями.
Джерела:
- Fungi Academy. Mushroom contamination: How to spot and what to do.
- Grow Magik. Trichoderma in monotub mushroom growing.
- Alchimia Grow Shop. Contamination in magic mushroom cakes, what to do and how to prevent it?









Будьте першим!